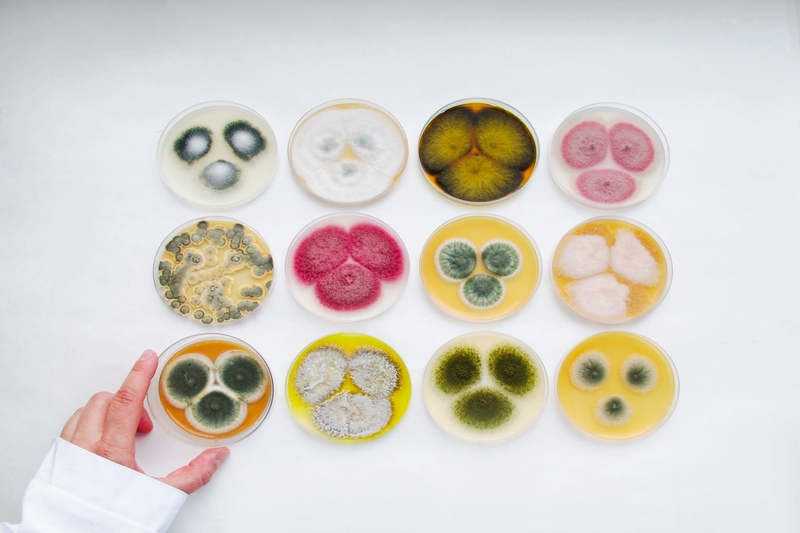

В НИЦ «Курчатовский институт» – ВИАМ состоялась церемония подведения итогов и награждения победителей корпоративного фотоконкурса «Наука в объективе». Проект стал не просто творческим состязанием, а настоящим праздником науки и искусства, объединившим сотрудников различных подразделений.
В течение месяца участники делились своим уникальным взглядом на научную деятельность, превращая сложные процессы и рабочие моменты в настоящие художественные произведения. Определение победителей проходило посредством открытого голосования в корпоративном Telegram-канале.
В торжественном мероприятии, состоявшемся в зале президиума, приняли участие авторы конкурсных работ, члены жюри и руководство предприятия. Генеральный директор Сергей Яковлев лично поздравил финалистов и вручил им заслуженные награды.
Победители в номинациях:
«Эстетика науки» — Анастасия Кривушина, старший научный сотрудник лаборатории, работа «Грибной микромир 1»;
«Люди науки» — Мария Лаптева, инженер 1 категории, работа «Исследовательница тайн»;
«Научный креатив» — Наталья Лонская, ведущий инженер, работа «Муравей в янтаре».
Без призов не ушли и финалисты конкурса:
Алексей Левченко, инженер 1 категории; Лариса Морозова, старший научный сотрудник лаборатории; Марина Скорикова, инженер 2 категории; Сергей Наприенко, заместитель начальника лаборатории; Дмитрий Горлов, ведущий инженер лаборатории.
Фотоконкурс стал ярким подтверждением того, что в научной работе, требующей точности и аккуратности, творческий взгляд помогает находить нестандартные решения и по-новому воспринимать привычные задачи. Каждая представленная работа — это не просто снимок, а отражение личного отношения автора к науке и его профессиональной деятельности.
Особенно ценно, что в проекте приняли участие как опытные сотрудники, так и молодые специалисты, что свидетельствует о преемственности традиций и живом интересе к творчеству в коллективе НИЦ «Курчатовский институт» – ВИАМ.